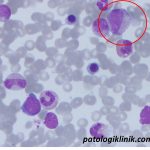
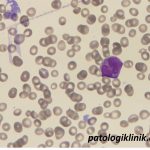
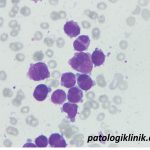
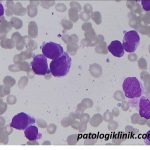
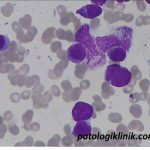

Beda Promielosit Normal dengan Promielosit pada APL/AML-M3
Karakteristik promielosit normal:
- 2-3x lebih besar dari eritrosit
- rasio inti : sitoplasma besar (sitoplasma lebih lebar dibanding mieloblas)
- inti bulat dengan kromatin imatur
- terlihat anak inti tapi kurang prominen dibanding mieloblas
- granula azurofilik pada sitoplasma
Pada leukemia promielositik akut (APL atau AML-M3), sebagian besar promielosit (>50%) abnormal:
- granula yang sangat banyak atau kasar, bisa sampai menutupi batas inti dengan sitoplasma
- inti berbentuk seperti ginjal atau bilobed (memiliki dua lobus)
- bisa terdapat Auer rod multipel, juga ada faggot cells (bundles of Auer rods)